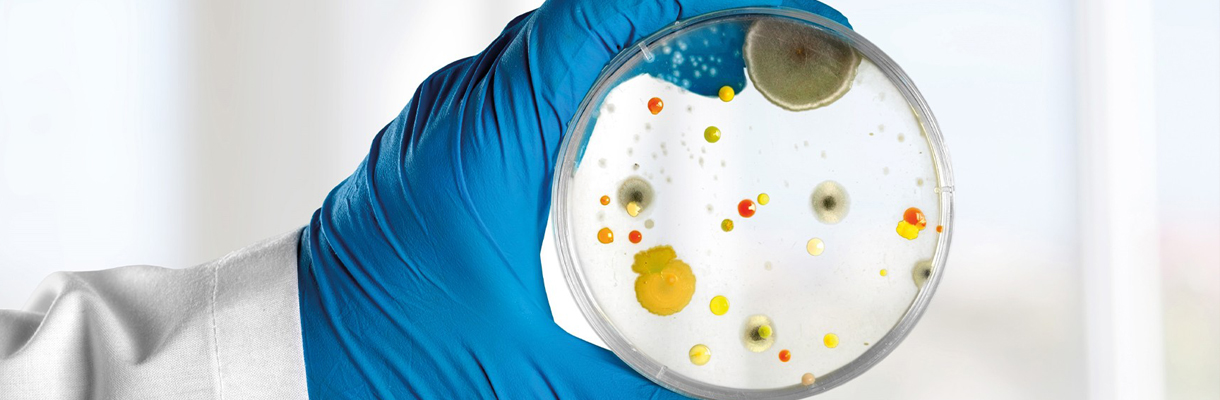

Infectious Diseases
Private MEVA Hospital
Infectious diseases refer to a medical field encompassing illnesses caused by microorganisms (bacteria, viruses, fungi, etc.). Infections can lead to numerous problems that threaten our health and cause serious consequences. As the Infectious Diseases Department, we are a team of specialists in the diagnosis and treatment of these diseases, and we are here to protect our patients’ health and fight infections.
The specialists working in our Infectious Diseases Department have extensive knowledge and experience in the diagnosis and treatment of infectious diseases. They deal with various infections, including bacterial infections, viral infections, fungal infections, parasitic infections, and other microbial diseases. They evaluate our patients’ symptoms and make the correct diagnosis using the necessary laboratory tests and imaging methods.
The specialists in our Infectious Diseases Department manage our patients’ treatment processes and prescribe appropriate medications such as antibiotics, antiviral drugs, and other anti-infective treatments when necessary. They also provide recommendations to strengthen our patients’ immune systems and increase their resistance to disease. During the treatment process, they aim to help our patients regain their health and prevent the spread of infections by providing continuous support.
The specialists in our Infectious Diseases Department also play an important role in preventing infections. They inform our patients about hygienic practices, vaccinations, and other measures to reduce the risk of infection. They also specialize in topics such as epidemiology and epidemic disease management, participating in efforts to protect public health.
In our Infectious Diseases Department, we aim to provide our patients with the best service using the latest medical technology and methods. We have advanced laboratory facilities, enabling us to make quick and accurate diagnoses. Furthermore, we strictly adhere to hygienic standards and meticulously follow infection control protocols to prevent the spread of infections. Our Infectious Diseases Department works with great dedication to protect our patients’ health, combat infections, and improve public health. Our team of experts is here to assist you with any questions or needs you may have regarding infectious diseases.












